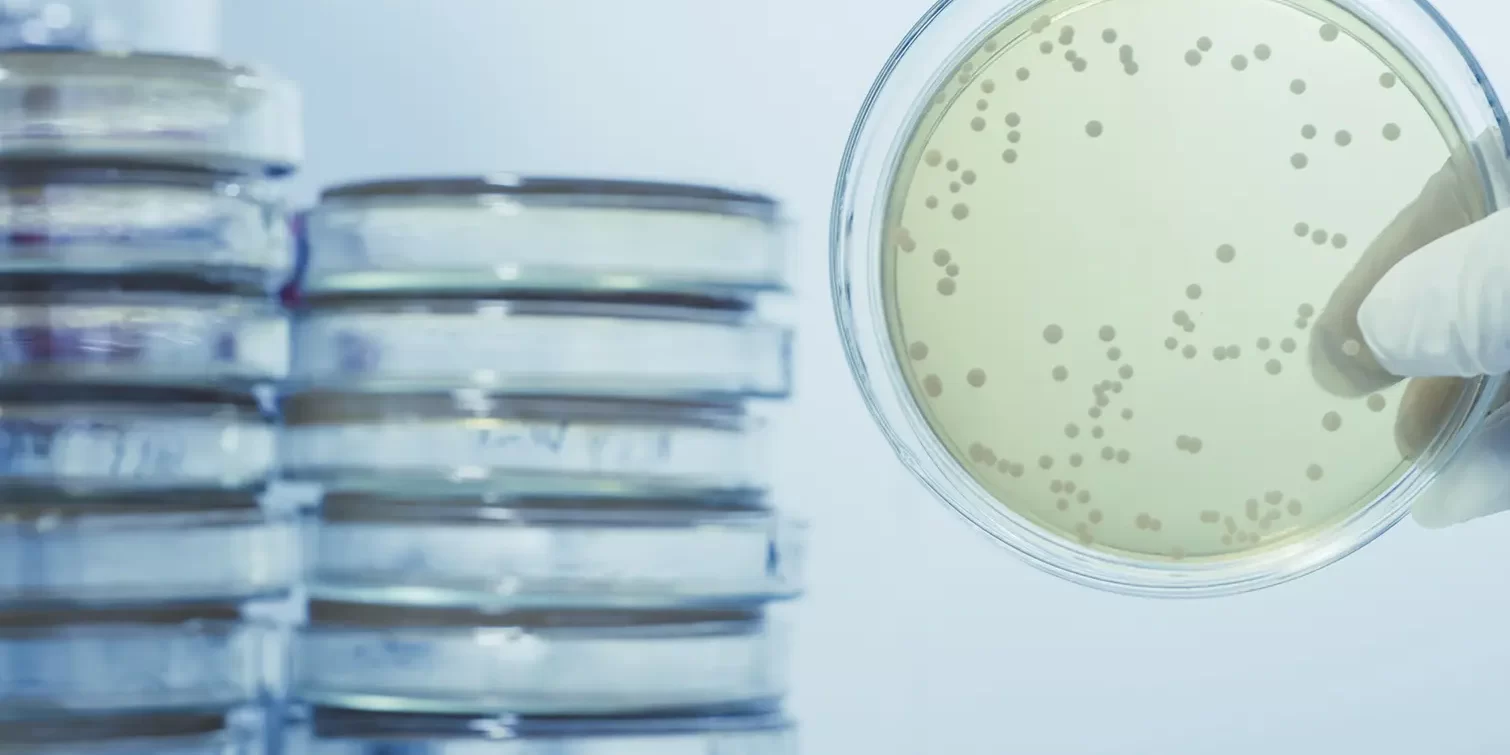
The Role of Chlorine Dioxide in Legionella Control The Role of Chlorine Dioxide in Legionella Control

Hospitals are vital for looking after our health, but they must also guard against Legionella bacteria, which can cause serious illness.
Making sure water systems in hospitals are clean and safe is key to stopping this bacteria from spreading and keeping everyone protected.
The Threat of Legionella in Hospitals
Legionella bacteria thrive in water systems, finding hospitable environments within hospital pipes, taps, and cooling towers. The complexity of hospital water systems, coupled with the compromised immune system of many patients, accentuates the need for an effective water treatment solution.
Chlorine Dioxide: A Proven Disinfectant
Chlorine Dioxide (ClO2) has emerged as a pivotal tool in the fight against Legionella within hospital settings. As a potent disinfectant, it boasts a broad-spectrum efficacy that eliminates the bacteria without the formation of harmful by-products.
Advantages of Chlorine Dioxide Over Traditional Methods
Unlike traditional chlorination, Chlorine Dioxide remains effective in varying pH levels and temperatures and does not react with organic compounds to form trihalomethanes (THMs), which are harmful when inhaled or ingested. This is particularly crucial in hospitals where safety and compliance with health regulations are paramount.
Scotmas: A Leader in Legionella Prevention
Scotmas leads the charge in implementing Chlorine Dioxide solutions for Legionella control in hospitals. By delivering bespoke ClO2 dosing systems, Scotmas ensures that complex healthcare water systems are kept free from the threat of Legionella.
Chlorine Dioxide in Action: Hospital Water Systems
The application of Chlorine Dioxide in hospital water systems is a strategic measure to prevent Legionella outbreaks. Scotmas’s precision-engineered dosing systems administer ClO2 effectively throughout the entire water network, offering continuous protection against the bacteria.
Meeting Health and Safety Standards
With Chlorine Dioxide, hospitals can not only meet but exceed health and safety standards. ClO2’s unique properties make it an ideal choice for environments where the risk of infection must be minimised, and regulatory compliance is non-negotiable.
The Scotmas Assurance: Chlorine Dioxide Solutions
Scotmas provides a comprehensive approach to Legionella control, offering end-to-end solutions from risk assessment to system implementation and monitoring. With Chlorine Dioxide’s proven track record in hospitals, Scotmas ensures that healthcare providers can maintain the highest standards of patient care and safety.
For hospitals looking to enhance their infection control protocols and safeguard against Legionella, Scotmas offers a trusted partnership. The efficacy of Chlorine Dioxide in managing waterborne pathogens positions Scotmas as a leader in hospital hygiene solutions. Contact us to discover how we can assist in fortifying your healthcare facility’s defences against Legionella.